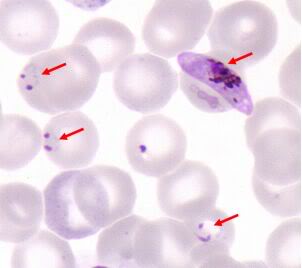

Bệnh sốt rét là bệnh truyền nhiễm cấp tính rất nguy hiểm do ký sinh trùng sốt rét gây nên và do muỗi Anophles truyền từ người bệnh sang người lành. Mặc dù trong vài thập niên qua, thế giới đã đạt được nhiều thành công trong việc kiểm soát bệnh làm giảm tỷ lệ mắc và tỷ lệ tử vong, tuy nhiên hiện nay bệnh sốt rét vẫn tiếp tục là mối quan tâm lớn trên toàn cầu đặc biệt là các quốc gia châu Phi.
Theo Tổ chức Y tế Thế giới (WHO), năm 2010 có khoảng 216 triệu người mắc và khoảng 655.000 trường hợp tử vong, tập trung chủ yếu ở trẻ em tại các quốc gia châu Phi.
Mặc dù bệnh sốt rét có thuốc điều trị, tuy nhiên việc sử dụng thuốc trong một thời gian dài cũng như việc sử dụng thuốc không hợp lý làm cho tình trạng ký sinh trùng sốt rét kháng thuốc đang gia tăng và lan rộng ra nhiều quốc gia trên toàn thế giới. Bệnh cạnh đó, các loại hóa chất sử dụng một thời gian dài trong phòng chống véc tơ cũng đã bắt xuất hiện giảm hiệu lực diệt, do muỗi Anopheles đã kháng hoặc tăng sức chịu đựng đang xảy ra ở 64 quốc gia lưu hành sốt rét (WHO, 2012). Vì vậy, việc nghiên cứu các giải pháp nhằm ngăn chặn sự mở rộng tình trạng ký sinh trùng kháng thuốc, cứu sống người bệnh cũng như ngăn chặn và kiểm soát véc tơ sốt rét kháng hóa chất là rất cấp thiết. Điều này cũng đặt ra nhiều thách thức cho các nhà khoa học trong việc tìm kiếm các phương pháp tiếp cận mới để kiểm soát chống lại bệnh nguy hiểm này.
Gen tế bào hồng cầu kiểm soát sự phát triển ký sinh trùng sốt rét?
Các nhà khoa học tại Trung tâm Y khoa thuộc Trường Đại học Duke (Mỹ) cuối cùng cũng đã phát hiện ra lý do tại sao những người bị bệnh hồng cầu lưỡi liềm khi mắc bệnh sốt rét thường nhẹ hơn so với những người có tế bào hồng cầu bình thường, phát hiện này sẽ là tiền đề trong việc lựa chọn phương thức mới để điều trị bệnh sốt rét.
Chi tiết kết quả công trình nghiên cứu này vừa được xuất bản vào ngày 15/8/2012 trên tạp chí Cell Host and Microbe.
Việc phát hiện này cũng đã chấm dứt một thời gian dài mà các nhà khoa học đã lảng tránh trong nhiều năm qua không giải thích được. Các nhà nghiên cứu tại Trường Đại học Duke đã phát hiện ra rằng vật liệu di truyền trong tế bào hồng cầu có thể giúp làm thay đổi hoạt động của ký sinh trùng, thông qua một cơ chế đặc biệt để làm thay đổi quy định gen ký sinh trùng sốt rét.
Tiến sĩ Jen-Tsan Chi tác giả chính và hiện là phó giáo sư tại Viện Khoa học hệ gen và Chính sách, Khoa Di truyền phân tử và Vi sinh vật thuộc trường Đại học Duke cho biết: "Một trong những phát hiện thú vị nhất trong công trình nghiên cứu này là microRNA con người (đơn vị rất nhỏ của vật liệu di truyền) được tìm thấy trong các tế bào hồng cầu lưỡi liềm và trực tiếp tham gia điều hòa gen của ký sinh trùng sốt rét". Những microRNA được cải thiện trong các tế bào hồng cầu lưỡi liềm làm giảm khả năng ký sinh trùng nhân lên vì thế mà cơ thể người bị bệnh hồng cầu lưỡi liềm được bảo vệ tốt hơn khi bị nhiễm ký sinh trùng sốt rét so với những người có tế bào hồng cầu bình thường.
MicroRNA là những đơn vị nhỏ của ARN, các microRNA là những đoạn ngắn, chiều dài chỉ khoảng 20-25 nucleotide và chúng có chức năng giúp điều hòa biểu hiện gen.
Các nhà khoa học cũng cho thấy rằng khi hai microRNA khác nhau được đưa vào ở mức độ cao hơn trong các tế bào hồng cầu bình thường thì sự phát triển ký sinh trùng trong cơ thể cũng giảm theo.
Tiến sĩ Jen-Tsan Chi cho biết: "Phát hiện này sẽ dẫn đến những hiểu biết sâu hơn về sự tương tác lẫn nhau giữa vật chủ-ký sinh trùng và vòng đời phát triển của ký sinh trùng sốt rét, từ đó làm cơ sở khoa học cho việc tiếp cận theo phương thức mới trong việc điều trị bệnh nhân sốt rét".
Greg LaMonte, một nhà khoa học tại phòng thí nghiệm của tiến sĩ Chi cho biết: "Kết quả nghiên cứu này sẽ mở rộng sự hiểu biết của chúng ta về sự tương tác giữa ký sinh trùng sốt rét và vật chủ nó, đây là cách thức tương tác hoàn toàn mới giữa vật chủ và ký sinh trùng. Điều này sẽ cung cấp cho chúng ta một sự hiểu biết rõ ràng hơn về chu kỳ sống của ký sinh trùng".
 |
Hồng cầu bình thường và hồng cầu lưỡi liềm (nguồn: learn.genetics) |
Ký sinh trùng sốt rét phát triển trong tế bào hồng cầu con người, các nhà khoa học nghĩ rằng các tế bào này không có bất kỳ vật liệu di truyền. Nhiều nhà khoa học đã tìm kiếm các thành phần trong các tế bào hồng cầu hình liềm điều này có thể giúp họ chống lại ký sinh trùng sốt rét.
Nhóm nghiên cứu thuộc Trường Đại học Duke đã tìm thấy các microRNA trong tế bào hồng cầu và cho thấy rằng thành phần của chúng có sự khác nhau đáng kể trong các tế bào hồng cầu lưỡi liễm. Trái ngược những gì mà chúng ta mong đợi, các nhà khoa học đã chỉ ra rằng những khác biệt sẽ đóng góp trực tiếp vào việc chống lại bệnh sốt rét ở những người mắc bệnh hồng cầu lưỡi liềm.
|
Ký sinh trùng sốt rét |
Các nhà khoa học cũng tiến hành một thí nghiệm khác cho thấy ngăn chặn các microRNA (đặc biệt là miR-451 và Let-7i) trong các tế bào hồng cầu lưỡi liềm làm giảm khả năng của các tế bào để bảo vệ chống lại bệnh sốt rét.
Tiến sĩ Jen-Tsan Chi cho biết: "Nếu chúng ta ngăn chặn các miRNA thì lúc đó ký sinh trùng phát triển hai hoặc ba lần".
Một bất ngờ khác trong nghiên cứu này là sự hợp nhất giữa microRNA con người với mRNA của ký sinh trùng. Sự hợp nhất ARN con người với ký sinh trùng là đại diện cho một hình thức độc đáo của sự tương tác giữa vật chủ-ký sinh trùng, và điều này có thể phản ánh một hình thức mới của miễn dịch tế bào vật chủ hoặc một cơ chế ký sinh trùng có thể thích ứng với môi trường tế bào vật chủ".
Phát hiện hai biến thể gen kháng lại bệnh sốt rét
Các nhà khoa học Đức và châu Phi vừa công bố kết quả công trình nghiên cứu trên tạp chí Nature vào ngày 15/8/2012 cho biết, các nhà khoa học đã phát hiện ra hai biến thể gen có khả năng kháng lại bệnh sốt rét. Phát hiện mới này là cơ sở khoa học giải thích lý do tại sao một số người ít mắc hoặc không bao giờ mắc sốt rét ác tính.
 |
Ký sinh trùng sốt rét đang phá vỡ hồng cầu (nguồn: medinfo.ufl.edu) |
Các biến thể gen mới được phát hiện sau khi các nhà khoa học tiến hành so sánh cấu trúc gen của 1.325 trường hợp mắc sốt rét ác tính do Plasmodium falciparum và 828 người đối chứng khỏe mạnh khác tại Ghana, quốc gia thuộc Tây Phi.
Biển thể gen thứ nhất được phát hiện trên nhiễm sắt thể 1q32 trong gen có tên ATP2B4. Gen này có chức năng vận chuyển canxi qua màng các tế bào hồng cầu, giúp ngăn chặn sự lây nhiễm ký sinh trùng sốt rét.  |
Cấu trúc ATP2B4 |
Trong khi đó, biến thể gen thứ hai được xác định trên nhiễm sắt thể 16q22.2, có thể liên kết với gen nằm cạnh mã hóa cho các protein MARVELD3, giúp kiểm soát protein lớp ngoài của mạch máu. Gen này đóng vai trò quan trọng giúp giảm nhẹ các tổn thương cho mạch máu khi các tế bào hồng cầu chủ bị mắc kẹt tại các mạch máu nhỏ, kết quả nghiên cứu trên đã mở ra liệu pháp mới điều trị bệnh sốt rét ác tính ở người, dựa trên sự so sánh kèm các phân tích mã gen, tìm kiếm những thay đổi nhỏ ở người bệnh, chẩn đoán chính xác những người có nguy cơ mắc bệnh cao. Từ đó giúp tìm ra các loại thuốc đặc trị mới chống lại bệnh sốt rét ác tính do Plasmodium falciparum, một dạng sốt rét nguy nhiễm nhất.
 |
a, b, ATP2B4 locus (a) and MARVELD3locus (b) as defined by the positions of SNPs showing a linkage disequilibrium of r2= 0.05 with the lead SNP rs10900585 (a; P= 6.1 × 10−9) and SNP rs2334880 (b; P = 3.9 × 10−8), respectively. Disease ass… (nguồn: Nature) |
Một số công trình nghiên cứu trước đây cũng đã chỉ ra rằng, những người thuộc nhóm máu O có khả năng kháng bệnh sốt rét do Plasmodium falciparum tốt hơn.
Phát hiện hợp chất chống ký sinh trùng sốt rét
Một nhóm các nhà khoa học quốc tế đứng đầu là các nhà khoa học trường Đại học San Diego (Mỹ) đã phát hiện ra một loại enzyme quan trọng liên quan đến sự tồn tại ký sinh trùng sốt rét. Việc phát hiện này là cơ sở để phát triển một loại thuốc chống sốt rét mới. Chi tiết công trình nghiên cứu vừa được xuất bản trên tạp chí Hóa dược (Journal of Medicinal Chemistry).
Các nhà nghiên cứu đã tiến hành phân tích gần 340.000 hợp chất tại Viện Quốc gia Mỹ và đã xác định một hợp chất quan trọng ngăn chặn sự phát triển ký sinh trùng sốt rét, Plasmodium falciparumglucose-6-phosphate dehydrogenase (PfG6PD). PfG6PD là một hợp chất quan trọng đối với sự nhân lên của ký sinh trùng sốt rét Plasmodium falciparum. |
ML276 (Nguồn: medicinal chemistry) |
Tiến sĩ Lars Bode cho biết: Enzyme xúc tác glucose-6-phosphate dehydrogenase (G6PD) là bước đầu tiên trong chu trình pentose phosphate (PPP), đây là chu trình trao đổi chất rất quan trọng đối với sự phát triển nhanh của ký sinh trùng sốt rét Plasmodium falciparum. Enzyme xúc tác bifunctional glucose-6-phosphate dehydrogenase-6-phosphogluconolactonase (PfGluPho) là bước thứ hai của chu trình PPP. Bởi vì Plasmodium falciparum và các tế bào hồng cầu vật chủ bị nhiễm dựa trên lượng glucose thay đổi, và chúng phụ thuộc vào sự hoạt động của G6PD PfGluPho. Vì vậy, nếu một người nào đó thiếu enzyme G6PD PfGluPho thì cơ thể sẽ tự bảo vệ khỏi bệnh sốt rét.
Hợp chất đầu tiên được xác định từ nỗ lực của các nhà khoa học là (R,Z)-N-((1-ethulpyrrolidin-2-yl)methyl)-2-(2-fluorobenzylidene)-3-oxo-3,4-dihydro-2H-benzo[b][1,4]thiazine-6-carboxamide (ML276). ML276 là một chất ức chế PfG6PD (IC50 = 889 nM), làm cho ký sinh trùng sốt rét trong hồng cầu giảm khả năng phát triển khi nuôi cấy trong điều kiện in vitro – thậm chí cả ký sinh trùng khác thuốc khác. Việc phát hiện ML276 là một cơ sở rất hứa hẹn cho việc sản xuất thuốc mới chống bệnh sốt rét trong tương lai.
Tài liệu tham khảo
1. http://www.nature.com/nature/journal/vaop/ncurrent/full/nature11334.html
2. http://www.ncbi.nlm.nih.gov/pubmed/22813531
3. http://www.sciencedaily.com/releases/2012/07/120719161859.htm
4. http://www.sciencedaily.com/releases/2012/08/120815121316.htm
5.http://pubs.acs.org/doi/abs/10.1021/jm300833h?prevSearch=PfG6PD&searchHistoryKey=
6. http://www.malaria.com/news/anti-malaria-drug-target
8. http://www.who.int/topics/malaria/en/
9.http://www.genetherapy.me/genetic-medicine/duke-scientists-discover-genetic-material-in-blood-cells-that-may-affect-malaria-parasites.php
10. http://www.topnews.in/health/new-atlas-charts-prospects-malaria-elimination-213421
11.http://www.vietnamplus.vn/Home/Phat-hien-hai-bien-the-gen-khang-lai-benh-sot-ret/20128/154455.vnplus
12. http://www.cualuoichongmuoi.org/search/?q=ML276&x=10&y=10
13.Bộ Y tế (2009), Cẩm nang phòng chống các bệnh truyền nhiễm,Hà Nội.
14. Viện sốt rét-KST-CT Trung Ương (2005), Dịch tễ học sốt rét và Quản lý chương trình phòng chống sốt rét, Nhà xuất bản Y học, Hà Nội.